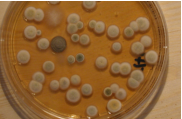

Sachverständigenbüro
für Umweltanalytik
und Baubiologie, Essen
Dr. rer. nat.
Thomas Haumann
Diplom-Chemiker,
Baubiologe IBN, VDB zert.
Radon-Fachperson
Am Ruhrstein 59
D-45133 Essen
Tel: +49 201 615 9862
Fax: +49 201 615 9863
thomas.haumann@gmx.net
www.drhaumann.de
Innenraumschadstoffe
Radon und Radioaktivität
Feuchte und Schimmelpilze
Partikel und Fasern
Raumklima und Gerüche
Elektromagnetische Felder
und Wellen
Untersuchungen
Beratung
Gutachten
Fortbildung
Vorträge
Forschung
Mitgliedschaften:
Fachverband für
Strahlenschutz e.V.
Verband Baubiologie e.V.
Berufsverband Deutscher
Baubiologen, VDB e.V.

Informationen
Auf unseren Internetseiten informieren wir Sie gerne über baubiologische Themen und
Untersuchungsmethoden in Bezug auf
•
Innenraumschadstoffe
=> Formaldehyd sowie leicht und mittelflüchtige Schadstoffe (VOC)
Ursache: Farben, Lacke, Kleber, Spanplatten, Holzwerkstoffe, Möbel, Einrichtungen, Geräte
Kunststoffe, Baumaterialien, Beschichtungen, Pflegemittel ...
=> Pestizide und andere schwerflüchtige Schadstoffe (SVOC)
Ursache: Holz-, Leder-, Teppichschutz, Kleber, Kunststoffe, Dichtungen, Beschichtungen,
Schädlingsbekämpfung, Kammerjäger ...
=> Radon
Ursache: Baugrund, Bauweise, Undichtigkeiten im Fundament, Bergbau, Baumasse,
Schlacken, Aschen, radiologische Hinterlassenschaften, Lüftung ...
=> Raumklima und Lüftung
Ursache: Feuchteschäden, Baufeuchte, Baustoffe, Lüftung, Heizung, Einrichtung, Atmung,
Elektrostatik, Strahlung, Staub, Umwelt ...
=> Partikel und Fasern
Ursache: Asbest, KMF, Aerosole, Schwebstoffe, Staub, Rauch, Ruß, Bau- und Dämmstoffe,
Lüftungs- und Klimaanlagen, Geräte, Toner, Umwelt ...
•
Radioaktivität
Ursache: Baumasse, radiologische Hinterlassenschaften, Steine, Fliesen, Schlacken,
Aschen, Antiquitäten, Glasuren, Kontaminationen, Bodenstrahlung, Umwelt ...
•
Schimmelpilze
Ursache: Feuchteschäden, Wärmebrücken, Baumängel, Baumaterialien, Sanierungsfehler,
Lüftungsmängel, Klimaanlagen, Einrichtung, Umwelt ...
•
Elektromagnetische Felder und Wellen (Niederfrequenz und Hochfrequenz)
Elektrische und magnetische Wechselfelder (Niederfrequenz)
Ursache: Wechselspannung in Installationen, Kabeln, Geräten, Steckdosen, Wänden,
Böden, Betten, Frei- und Hochspannungsleitungen... Wechselstrom in Installationen,
Kabeln, Geräten, Trafos, Motoren, Frei- und Erdleitungen, Hochspannungsleitungen, Bahn...
Elektromagnetische Felder und Wellen (Hochfrequenz, Mobilfunk)
Ursache: Mobilfunk, Daten-, Bündel-, Flug-, Richt-, Rundfunk, Radar, Militär, drahtlose
Netzwerke (WLAN), Bluetooth, Schnurlostelefone (DECT), Funkgeräte...




© Dr. Thomas Haumann 01/2021







